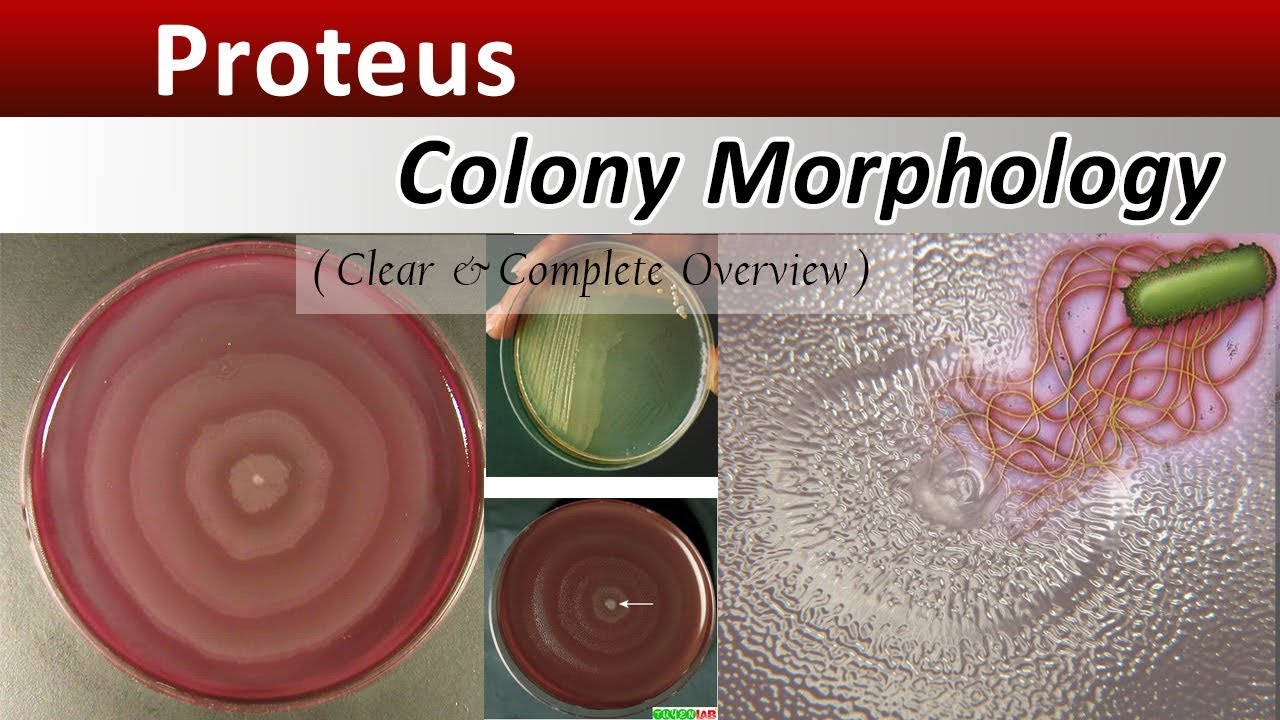

Тест протей
Солоники лагерь
Научный стиль я класс
Помидор золотое яблоко
The can do a favour
Перец чипотле в соусе адобо
Тропикамид холиноблокатор
Развлекательный бот в телеграмме
Как проверить слово вписал
Bios is corrupted
Скорость интернета i
Мой цветок москва
Участники регионального этапа всош 2024 2025
Где упаковать коробку
Тест протей 113 фотографий